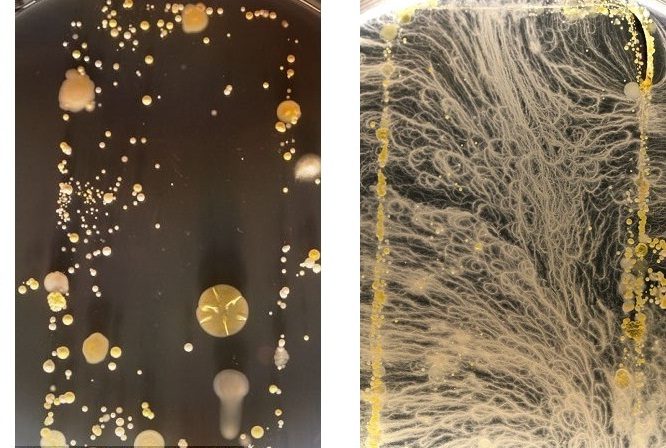
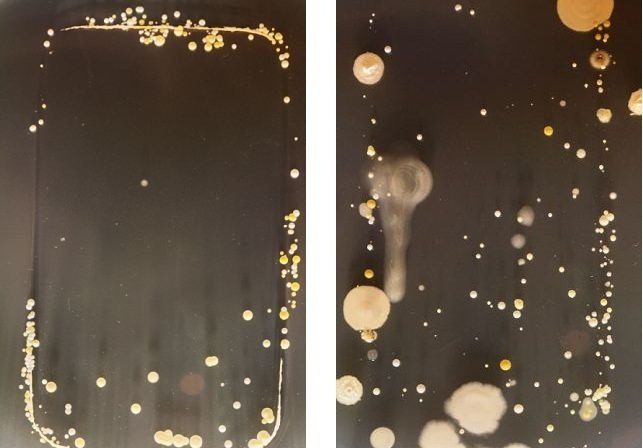

Il y a environ deux ans et demi, une étude de l’université de Manchester montrait que les mobiles étaient des nids à microbes. Aujourd’hui, le travail d’étudiants de l’université de surrey en Grande-Bretagne le prouve en images. Les étudiants en bactériologie se sont livrés à une expérience originale dont le Daily Mail se fait l’écho. Ils ont posé leurs smartphones sur des boîtes de Pétri pour voir ce que leurs appareils pouvaient transporter comme bactéries.
Au bout de trois jours de culture le résultat a été étonnant. Heureusement, la plupart des bactéries relevées étaient inoffensives. Mais tout de même. Cela montre bien que les smartphones sont de vrais bouillons de culture ! Malgré tout quelques bactéries dangereuses ont été trouvées comme le staphylocoque doré. Il peut être responsable d’intoxications alimentaires, d’impetigo et même entraîner une septicémie. Il faut dire qu’en moyenne, ce germe est présent au niveau des fosses nasales et de la gorge chez 20 % des individus sains.
Les bactéries utilisent de multiples vecteurs pour se multiplier. L’eau, la nourriture, les insectes et les téléphones. Le module universitaire intitulé Bactériologie pratique et biomédicale est « un moyen très efficace de faire prendre conscience aux élèves de l’existence d’une microbiologie souvent négligée de leur vie quotidienne », a assuré le maître de conférence du module, Simon Park, au Daily Mail. Ainsi sur un des mobiles il a pu déceler le Bacille mycoide qui se développe habituellement sur le sol. Il a donc pu en conclure que l’appareil ou son propriétaire avait été récemment en contact avec de la terre.
Finalement un téléphone ne retient pas que vos messages ou vos numéros préférés, mais il héberge aussi tout un historique de vos contacts avec d’autres personnes ou d’autres matières.
Source : Daily Mail
👉🏻 Suivez l’actualité tech en temps réel : ajoutez 01net à vos sources sur Google, et abonnez-vous à notre canal WhatsApp.

